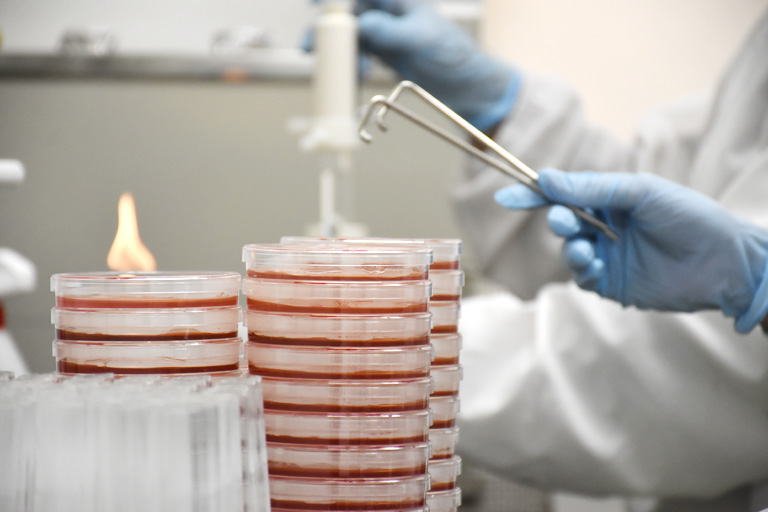

商品、原料の菌数検査
毎日の工場内で生産した商品の菌数検査、開発商品、使用原材料

品質管理への具体的取り組み
毎日の工場内で生産した商品の菌数検査、開発商品、使用原材料

工場内で生産した商品の菌数検査を行い、安全な商品の出荷を確立します。

会社全体で「食品衛生」の基本知識を習得するため、外部講師を招き、衛生教育を行い、衛生教育を通して、生産現場で必要な食品衛生の知識と食品従事者としての責任と高い意識を身に付けてもらいます。